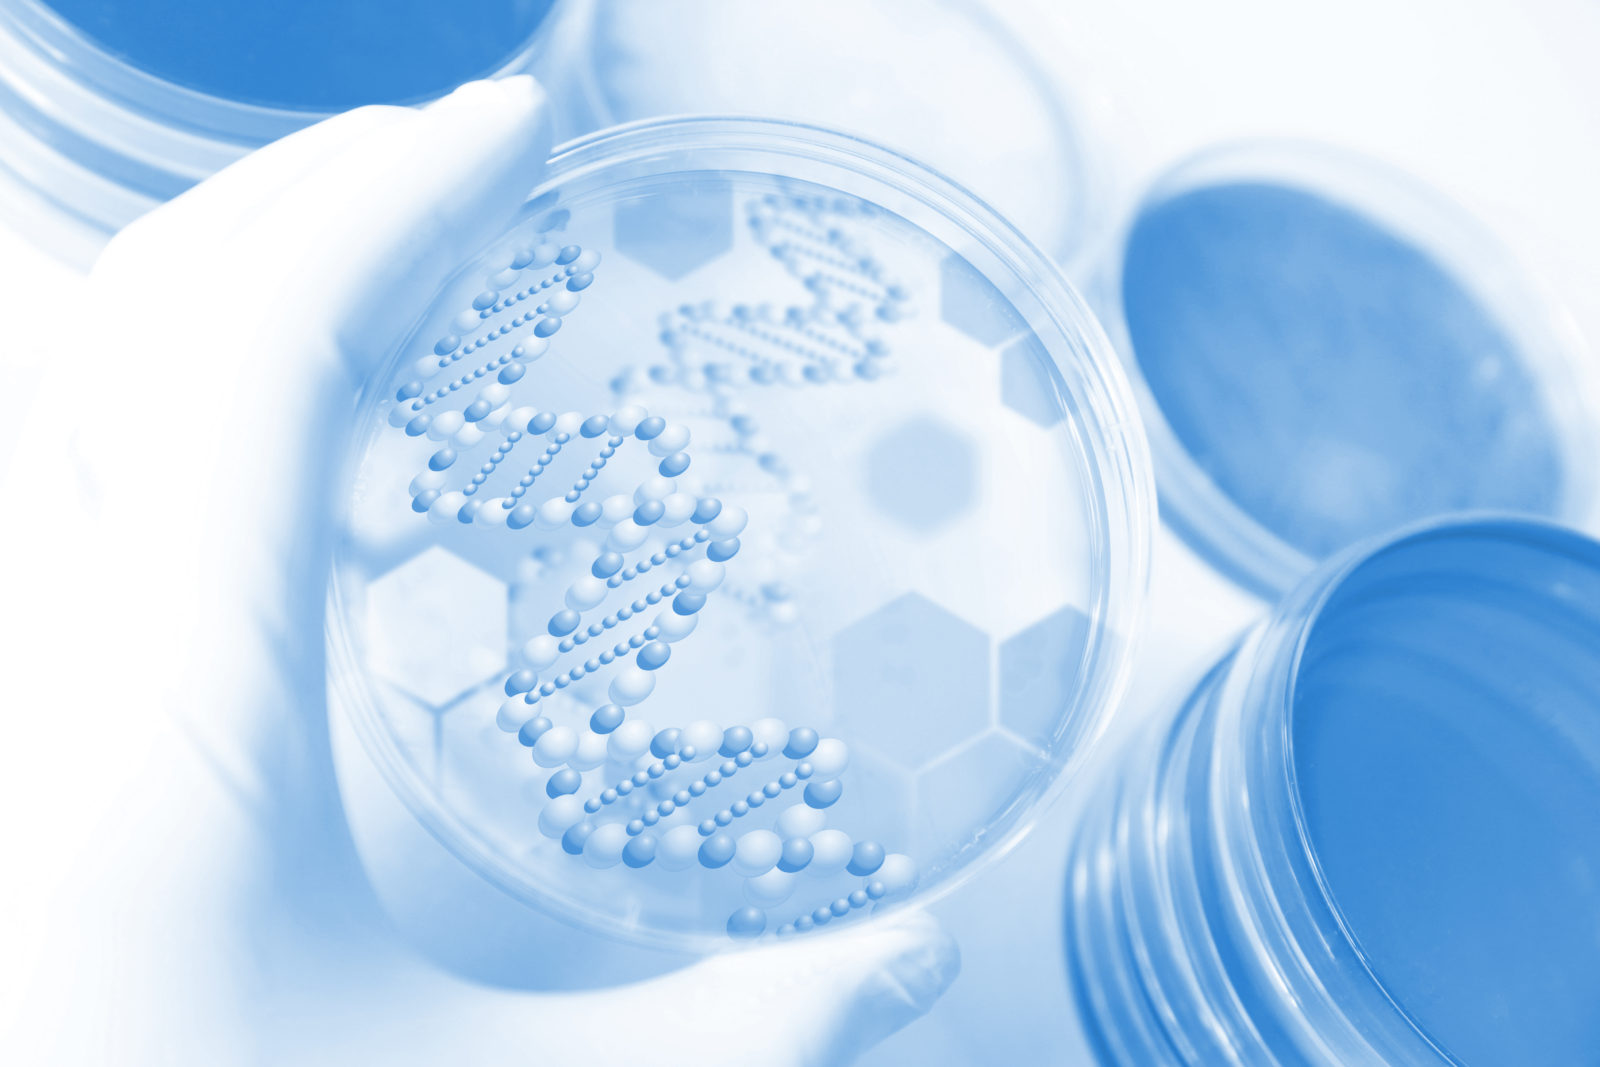
画像

歯周病学会「認定医」が在籍
お口の問題、精密検査で早期発見します
歯の病気を予防する「口腔精密検査」
「歯科ドック」は「人間ドック」と同じ概念です。自覚症状のない歯の異常を検出するための「口腔精密検査」を行います。保険適用の検査では、通常は既に「痛みがある」「腫れている」「歯が欠けた」などの問題に対応する検査が行われます。「口腔精密検査」では、将来的に問題となる可能性のある箇所を特定し、現在自覚症状のない細菌感染や噛み合わせの問題も検査します。具体的にどのような検査を実施するのか、以下で詳しくご紹介いたします。
検査項目のご紹介
口腔外検査
口腔内検査
1歯科軟組織検査
歯科軟組織とは、歯肉などの粘膜や歯髄などのことを指します。歯科軟組織検査を行うことで、歯周病などの早期発見につながります。
2歯ぎしりや咬合性外傷の検査
歯周病と似た病気に咬合性外傷(こうごうせいがいしょう)と呼ばれるものがあります。歯や歯周組織に過度な力が加わることによって生じるため、特に歯ぎしりなどがある場合は、咬合性外傷でないかをしっかり検査します。
3虫歯診査
4歯肉診査
歯肉の色や状態、出血の有無、排膿(膿が出ているか)、歯間乳頭(歯と歯の間部分の歯肉)などを検査し、歯周病の有無、進行状況を確認します。
5歯周ポケット検査
歯周ポケットの深さをはかり、歯周病の進行度を確認します。
6レントゲン検査(パノラマ、デンタル14枚法)
パノラマレントゲン、デンタル14枚法による撮影を行い、目では見えない虫歯や歯周病の進行度合いや治療状態などを確認します。
7歯列模型
患者さんの歯型を採取し、模型で可視化し、確認します。
8血圧・脈拍測定
9口腔内写真
これらの検査方法を行うことで、お口から全身の健康を守るプログラムを行うことができます。
細菌検査/その他の検査
お口の中の疾患の多くは細菌感染が原因です。治療前に、現在お口の中にどのような細菌がどれだけ存在しているのかを把握することは非常に重要です。また、治療の途中や終了後にも検査を行うことで、注意すべき点など多くのことがわかります。当院では、細菌感染によって生じる歯周病、虫歯について、それぞれ次の細菌を調べています。
歯周病菌検査(歯周病関連菌)
下記の細菌の確認を行います。
・Actinobacillus actinomycetemcomitans
・Porphyromonas gingivalis
・Prevotella intermedia
・Bacteroides forsythus (Tannerella forsythensis)
・Treponema denticola
・Fusobacterium nucleatum
虫歯菌検査(虫歯関連菌検査)
下記の細菌の確認を行います。
・総レンサ球菌数
・ミュータンス菌数
・う蝕比率
・乳酸取得菌数
唾液検査
・Dentocult SM
う蝕のきっかけをつくるミュータンス菌(虫歯原因菌)の数を測定するための検査キットです。
・Dentocult LB
う蝕を進行させる口腔内のラクトバチラス菌(乳酸菌)の数を測定する検査キットです。
・Dentobuff Strip
唾液の緩衝能(酸中和力)を測定するための検査キットです。
・Dentocult CA
口腔粘膜に炎症を引き起こすカンジダ菌の存在を検出する検査キットです。
サリバテスト
唾液を用いて口腔内の健康状態を評価する検査です。虫歯や歯周病のリスク、唾液の量や質、pHなどを短時間で測定し、予防や治療に役立てます。
口臭検査
リアライズ口臭検査キットは、口腔内の不快な口臭の原因成分を総合的に分析し、お口のにおいを4段階で判定します。
自宅で手軽に検査ができるため、口臭が気になる方だけでなく、ご家族の口臭で悩んでいる方にも役立ちます。
検査の流れ
STEP1問診/応急処置
最初に患者さんが感じている痛み、違和感などの「お話」をお聞きし、「簡単な検査」を実施します。
どんなことでも気になる症状がある場合はお伝えください。また、このような治療がしたいなど希望がある場合もお伝えいただければ、ご要望に沿った対応をするように致します。
STEP2さまざまな検査
ここまでにご紹介してきた「各種検査」を行います。
さまざまな検査を行いますので、自分では気づかない問題や将来現れそうな問題が見つかると思います。
STEP3検査結果の説明
さまざまな資料を見ながら「検査結果」をていねいにご説明いたします。
もちろん問題がある箇所や、リスクについてもご説明します。疑問や不明点を残さないようご質問ください。
STEP4お見積もり
最適な治療法と、それにかかる治療費をご提示させていただきます。
治療方法と費用をご確認いただき、その治療を実際に行うかどうかは、患者さんのご判断となります。当院で勝手に治療を進めるようなことはありませんのでご安心ください。
STEP5治療開始
治療方法や費用についてご確認いただき、患者さんがご納得された場合、この時点から治療を進めていきます。
初診「個別」相談へのご案内
当院では、患者さんが抱えていらっしゃるお口のお悩みや疑問・不安などにお応えする機会を設けております。どんなことでも構いませんので、私たちにお話ししていただけたらと思います。
ご興味がある方は下記からお問い合わせください。